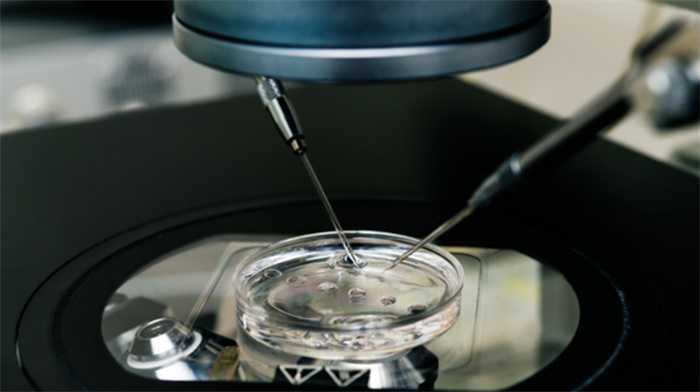

女子生龙凤胎 女儿却与丈夫无血缘 患有先天性双耳聋
近日,一女子通过试管婴儿技术生下龙凤胎,其中一个孩子竟然与自己的丈夫毫无血缘关系,这起事件发生在湖北,事件当事人秦某对记者描述,自己在去年前往一家生殖专科医院进行辅助生殖治疗,医院称移植一个胚胎,后来发现体内竟然有两个孕囊,最终是生下了一对龙凤胎,不过让他难以接受的是,龙凤胎的女孩出生不久就被诊断为先天性双耳全聋,而且女儿只和自己有关系,与丈夫没有任何的血缘关系,另外一个男孩则是自己和丈夫亲生的孩子。

此事曝光之后,受到了社会各界的关注,该女子要求该医院承担女儿一共人工耳蜗等一系列的治疗恢复费用,而医院方则针对此事表示,经过院方自查,先前手术不存在任何的差错,女子索要赔偿可以通过司法途径解决问题。不过秦女士对医院的说法不予认同,在二月28日前往湖南省卫健委信访办,反映了此次事件相关的问题,后续经过工作人员的协调,秦女士在卫健委和该医院达成了初步协议。
根据双方的协议称,医院会用20天的时间进行内部调查,如果在调查期间没有找出秦女士方面的各项原因,为了秦女士女儿的健康,会由医院先期垫付孩子的手术治疗费用,具体的数额会根据手术所在医院的治疗方案以及相关的费用预算来规定,并在确定治疗费用之后的三日内进行支付,在此次协议中还强调秦女士女儿的治疗时间必须以就诊医院的专家建议为准。

在公开资料中显示,秦女士做辅助生育手术的医院是中信湘雅生殖与遗传专科医院,这家医院是在2002年正式组建的,是全国第一家获得卫生部批准的人类辅助生殖技术专科医院,也是国内首家三级生殖与遗传专科医院,截止到2022年的七月份,在这家医院当中出生的人工助孕健康婴儿超过了20万个。
大家都在看
-
揭秘古代那些被历史遗忘的荒唐秘闻,笑到肚子疼的古代奇闻趣事 引子:历史的另一面——不一样的古代大家好!今天我们要翻开那尘封的古代史书,带你领略那些“正经”史书之外的“野史秘闻”。这里没有皇帝的高大上,也没有将军的威风凛凛,只有一些荒诞不经、令人啼笑皆非的奇闻趣 ... 奇闻怪事12-07
-
世界之大无奇不有,19张照片带你看不一样的奇闻趣事 电驴承重、角马反击、珍妮海报,三个词在同一页被刷到,很多人点开只是好奇,更多人关心背后的问题,一段电动车超载的视频提醒了安全,一段角马对狮子的回身让人叹气,一个旧电影片头的人物又被重新提起,这些看起来 ... 奇闻怪事11-28
-
奇闻,你听到过吗? 奇闻,你听到过吗?这年头遇事找律师本是求个公正靠谱,盼着靠专业力量化解难题,可偏偏有人撞上个离谱糟心事——遇上收钱不办事、最后直接玩失踪的无良律师,这般操作颠覆认知,属实让人咋舌。生活里难免有纠纷缠身 ... 奇闻怪事11-21
-
揭秘鲜为人知的历史秘闻:那些令人惊叹的奇闻趣事,你知道吗? 历史长河中藏着许多鲜为人知的秘密和趣味故事,等待我们去挖掘。今天,就让我们一同穿越时空,揭开那些令人惊叹的历史细节,带你领略不一样的古今奇闻。1. 拿破仑的“迷你”军队:隐藏在战场背后的秘密武器众所周知 ... 奇闻怪事11-20
-
国画秘史:那些令人咋舌的奇闻巧合 在浩如烟海、璀璨绚烂的国画世界里,不仅有艺术家们鬼斧神工般的精湛技艺和深邃幽远的思想表达,还隐匿着众多令人拍案称奇的巧合与动人心魄的奇闻异事。这些故事宛如历史长河中熠熠生辉的璀璨明珠,轻轻拂去岁月的尘 ... 奇闻怪事11-13
-
世界之大无奇不有,18张照片带你看不一样的奇闻趣事 1.美国内战时,一颗子弹正中士兵雅各布•米勒的眉心。子弹没有打穿米勒的脑袋,而是停留在他的额头。31年后,子弹从米勒的额头自动脱落。2.玛丽莲·梦露这个名字已经超越了演员的范畴,她成为某种文化符号的具象化存 ... 奇闻怪事11-10
-
世界之大无奇不有?20张照片带你看不一样的奇闻趣事 73%的假动作成功率,比任何羚羊都高——跳羚靠这招把狮子耍得原地打转。纳米比亚保护区刚放出的高速摄影里,它急刹时蹄子蹭地那声“呲啦”,像给捕食者按了暂停键,回声再一叠,狮子直接失去锁定。我盯着循环播放, ... 奇闻怪事11-07
-
世界之大无奇,16张照片带你看不一样的奇闻趣事 1.这块“钛水晶”可以说是金属届的孔雀,色彩一层层闪变,从蓝到金再到紫,像被宇宙染过色。美得像假的,偏偏真得耀眼2.这是索多玛苹果(Calotropis procera),外号“迷惑果”。汁液含剧毒乳胶,连动物都避而远之。 ... 奇闻怪事11-03
-
网上疯传的“乡村奇闻”,每一件都炸裂你的三观 现在刷短视频早成了全民日常,排队、通勤、睡前的碎片时间,大家总爱掏出手机划一划,既能打发时间,又能看看外面的世界。可这便捷背后,却藏着不少让人哭笑不得的现象:随着创作门槛降低、AI工具普及,越来越多人为 ... 奇闻怪事10-31
-
世界之大无奇不有,20张照片带你看不一样的奇闻趣事 跳羚的假动作成功率78%,不是靠运气,是靠“课后补习”。非洲草原的跳羚数量15%的涨幅,背后是一整套“补习班”机制:小跳羚先围观成年跳羚怎么“晃鳄鱼”,再自己上场练,练错了就挨鳄鱼一口,练对了就留下基因。科 ... 奇闻怪事10-29
相关文章
- 世界之大无奇不有,20张照片带你看不一样的奇闻趣事
- 以下是一些最近发生的奇闻趣事:
- 以下是一些最近的奇闻趣事:
- 关于汽车的奇闻异事
- 四篇古代奇闻:欲望与抉择背后的命运
- 揭秘唐朝五大野史趣闻:贵妃袜、放屁税、梦境预兆与民间奇闻
- 历史上的奇闻异事:探寻那些令人瞠目结舌的历史故事
- 世界之大无奇不有;带你看不一样的奇闻趣事
- 笑到肚子疼的民间趣事:那些让人忍不住爆笑的奇闻轶事
- 他赴美留学,却在学校边上惨遭杀害,留学生纪欣然案全复盘
- 古典奇闻小故事五则
- 五段历史奇闻,巧合如影随形,世界是否在重复轮回?
- 历史上5个真实发生的奇闻异事,每一个都颠覆认知,至今仍有谜团
- 古典奇闻小故事六则
- 古代奇闻故事五则
- 身边的奇闻趣谈:灵异、鬼故事与中元习俗
- 那些让人惊掉下巴的奇闻轶事
- 探秘古代人奇闻异事:那些超乎想象的趣事
- 现代奇闻:4 件怪事藏着不一般的暖与真
- 历史奇闻录:从明朝飞书到水下打火机,古人趣事知多少
热门阅读
-
日本gv公司盘点,高质量钙片清秀型美攻美受 07-11
-
盘点中国十大龙现身事件,真龙竟然屡次现身震惊众人 06-27
-
戴旭说出马航失联真相,因为害怕承担责任迟迟不公开 07-05
